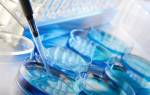

Древние славяне считали опасным удалять мудрые зубы, ведь вместе с ними человек лишался покровительства предков. Сегодня, если они растут неправильно, доставляют боль, врачи рекомендуют удаление. Зуб мудрости не важен для нормального пережевывания пищи. Он может вызвать воспаление десны, смещение ряда.
Строение и расположение
Зуб мудрости еще называют третьим корневым моляром или восьмеркой. Он закрывает ряд на верхней и нижней челюсти, внешне не отличается от других жевательных зубов – широкий, имеет углубленную в центре и волнообразную по бокам структуру.
Корни зуба мудрости глубокие. Они имеют изогнутую форму и могут срастаться между собой. Это создает проблему при лечении кариеса и других заболеваний. Иногда при развитии челюстей зубные задатки меняются местами, тогда вместо мудрого зуба со сложной коневой системой прорезывается клык с одним корнем, но плоской верхушкой.

Мнение врачей:
Прорезывание и удаление зубов мудрости – процедуры, требующие особого внимания и профессионализма со стороны стоматологов. Врачи отмечают, что прорезывание зубов мудрости может сопровождаться различными осложнениями, такими как воспаление десен, болезненность и отек. Поэтому важно своевременно обращаться к специалистам для оценки состояния зубов мудрости и принятия решения о необходимости их удаления.
Удаление зубов мудрости также требует особого подхода. Врачи подчеркивают, что данная процедура может быть сложной из-за особенностей анатомии зубов мудрости и их расположения. Поэтому важно доверить эту задачу опытному специалисту, который сможет провести процедуру без осложнений и минимизировать риск возможных осложнений после удаления.

Физиологическое значение
В рационе древних людей преобладала твердая, жесткая пища – коренья, плоды, слабо прожаренное или сырое мясо. Чтобы их пережевывать, природа наделила человека дополнительными жевательными зубами, которые сейчас называют мудрыми. Они были плотнее и тверже, чем «соседи» и могли размалывать даже самую грубую пищу и кости.
Сегодня восьмерку называют рудиментарной (часть тела, которая с течением времени утратила свою значимость). Пища проходит полную термическую обработку, а большая часть составляющих блюда – мягкие овощи или каши. Такой рацион делает зубы мудрости лишними. Они представляют ценность, только если растут ровно или используются для создания мостовидного протеза.
Особенности прорезывания
Мудрые зубы закладываются не в утробе матери, как остальные, а в 4-5 лет. Их отсутствие считается не дефектом скелета, а вариантом нормы. Такое название связано с тем, что они вырастают значительно позже резцов, клыков. Наличие или отсутствие восьмерок, а также время их появления, зависит от наследственных факторов, размеров и формы челюсти. Прорезаться восьмерки могут как к 13, так и к 40 годам.
Когда вылезают зубы мудрости, появляются неприятные симптомы:
- зуд в области прорезывания;
- воспаление и отек десны;
- ноющая или пульсирующая боль, которая усиливается во время пережевывания пищи;
- повышение температуры тела на 1-2 градуса;
- воспаление лимфатических узлов под челюстью.

Чаще для третьих моляров не хватает места, чтобы нормально развиваться, поэтому они прорезываются частично или остаются под десной. Иногда коренной зуб растет неправильно, а под углом к соседу, задней части рта или врастает в корни другого.
Статьи по теме
- Аналоги Солкосерила по фармакологическому действию и составу
- Лечение зубов при беременности – когда и как безопаснее проводить, противопоказания и ограничения
- Ибуклин – инструкция по применению для детей и противопоказания, побочные эффекты, дозировка и аналоги

Опыт других людей
Прорезывание и удаление зубов мудрости – процессы, вызывающие много волнений у людей. Многие отмечают, что прорезывание мудренцев сопровождается болезненными ощущениями и отечностью десен. Однако, несмотря на временные неудобства, большинство соглашается, что после заживления процесса дискомфорт уходит, и зубы мудрости становятся полезными. Что касается удаления, многие высказывают опасения относительно процедуры и последующего болевого синдрома. Тем не менее, современные методы обезболивания и профессиональные навыки стоматологов делают этот процесс более комфортным и безопасным. Важно помнить, что забота о зубах мудрости требует внимания и своевременного вмешательства специалистов.
Показания к удалению
Решение о необходимости иссечения части десны или всего зуба принимает стоматолог. Если начали прорезываться дополнительные моляры, появилась сильная боль или кровоточивость десен, обратитесь к врачу. Он направит на рентген челюсти. По снимку можно определить расположение, оценить длину корней и другие факторы.
Восьмерки обязательно удаляют, если есть проблемы:
- Ретинированный зуб, который не может прорезаться из-за недостатка места на челюсти. Иногда моляры вырастают только частично, буграми. Такое состояние чревато развитием пародонтита (воспаления тканей десны).
- Проблемы с прорезыванием. Моляр растет вне ряда или упирается в щеку, соседние коренные.
- Мудрые зубы могут уже прорезываться с кариесом, но из-за неудобного расположения и сложного строения корней стоматологу проблематично поставить пломбу или провести профилактическое лечение.
- Киста– полость, наполненная жидким содержимым. Появляется она у основания зуба, может привести к ущемлению нервов, сильной боли и другим осложнениям. Кисты удаляют хирургическим путем.

Симптомы поражения
Если растет зуб мудрости, и он уже поврежден кариесом или прорезывается криво, часто развивается перикоронит. Это воспаление окружающих мягких тканей. Лечат его путем иссеченияверхней части десны или полного удаления восьмого моляра.
Без стоматологической помощи у человека могут появиться симптомы инфицирования:
- красная, опухшая ткань десны и щеки;
- боль при надкусывании или пережевывании твердой пищи;
- неприятный привкус или запах изо рта;
- выделение гноя и дренирование (появление дырок в десне);
- травмы щек и языка;
- боль в ухе или голове;
- флюс – нарыв на щеке или сбоку на десне.

Возможные осложнения
При неправильном росте иногда возникают неприятные последствия:
- Повреждение челюсти. Вокруг восьмерок образуются кисты, которые могут привести к воспалению и повредить нервы.
- Проблемы с соседними зубами. Дополнительный набор моляров приводит к смещению ряда и неправильному прикусу.
- Разрушение. Неудобное расположение зубов мудрости препятствует полноценной чистке. Из-за недостатка гигиены между десной и моляром скапливаются остатки пищи, бактерии, развается гингивит (воспаление десны).
- Остеомиелит– гнойное заболевание костной ткани челюсти.
- Образование карманов. Если зуб восьмерка прорезался не полностью, между десной и костной частью челюсти создается пространство. Это благоприятное место для скопления пищи и бактерий.
- Флегмона– гной между десной и зубом или в щеке.
Процедура удаления
Стоматолог может порекомендовать избавиться от зубов мудрости еще до появления каких-либо проблем. Это делается для того, чтобы избежать очень болезненного и сложного извлечения, которое потребуется через несколько лет. Удаление легче проводить у молодых людей. Пациентам в возрасте от 50 лет может потребоваться больше времени для восстановления.
Относительная легкость, с которой хирург извлечет восьмерку, зависит от ее положения и стадии развития. На предварительном осмотре врач рассказывает пациенту, чего ждать во время операции, как проходить реабилитацию. Мудрый зуб, который не прорезался через десну, удалить сложнее. Сначала доктор снимет верхнюю часть мягких тканей, а затем вытащит моляр. Часто удаление проводят кусочками, чтобы минимизировать количество срезанной десны.
Этапы
Перед операцией происходит встреча с хирургом, на которой пациент:
- Говорит о любых проблемах со здоровьем.
- Перечисляет лекарства, которые принимает на постоянной основе.
- Задает интересующие вопросы об операции. Обсуждает тип анестезии (обезболивания).
Сама процедура не занимает дольше 45 минут, состоит из нескольких этапов:
- В кресле хирург делает пациенту укол в десну или вводит обезболивающее средство по вене, чтобы вызвать сонливость, снять боль.
- Через 3-5 минут, когда анестезия подействовала, при помощи специальных стоматологических инструментов проводит удаление. Если восьмерка выросла не полностью, то сначала разрезается десна, затем извлекается костная ткань.
- Ранка после мудрого зуба большая, поэтому ее края сшивают.

Боль и дискомфорт от операции проходят в течение нескольких дней, но на полное заживление понадобиться 2-3 недели. Все по-разному реагируют на анестезию. Если во время операции использовалось местное обезболивание, пациент может сразу поехать домой. При общем наркозе врач оставит больного в клинике для наблюдения на два часа.
Восстановление
Скорость заживления лунки зависит от степени сложности операции. При прорезавшемся моляре процесс протекает быстрее, чем при удалении вместе с частью десны. Если для соединения краев лунки использовались нерассасывающиеся нити, нужно через неделю посетить стоматолога для снятия швов.
Чтобы ускорить восстановление, придерживайтесь рекомендаций:
- Для снятия отека лица приложите на 10 минут пакет со льдом, завернутый в ткань.
- При сильной боли принимайте нестероидные противовоспалительные средства, например, Ибупрофен.
- В первые 24 часа откажитесь от чистки ближайших к лунке зубов, полоскания рта.
- Если десна загноилась до удаления, после операции продолжайте принимать антибиотики или спросите врача о необходимости их назначения.
- Пока не исчезнет онемение от наркоза, пейте только воду. Через несколько часов разрешено есть суп, желе, мягкие яйца. На 1-2 недели откажитесь от алкоголя, курения и твердых продуктов (семян, орехов, мяса).
- После еды и перед сном ополаскивайте рот теплой соленой водой (1/2 ч. л. соли на 1 стакан жидкости).
Риски
После удаления дополнительных коренных зубов возможны осложнения:
- Кровотечение, которое иногда возникает в первые нескольких часов после операции. Чтобы контролировать состояние, поместите кусочек чистой влажной марли на пустое зубное гнездо и плотно прижмите. Если кровотечение слишком сильное, обратитесь к врачу.
- Парестезия. Иногда во время удаления повреждаются ближайшие нервы, из-за чего возникает онемение языка, губ, щек, подбородка. Такое осложнение проходит в течение нескольких дней или недель. При серьезном повреждении нервов онемение может остаться навсегда.
- Сухая лунка. После изъятия моляра на его месте образуется сгусток крови. Он защищает кость и нервные окончания от бактерий, внешнего воздействия. Если сгусток не образовался или смещен, заживление будет происходить дольше, возможно воспаление, проникновение инфекции.
- Повысшение температуры на 1-2 градуса– это реакция организма на травму. Соблюдайте правила гигиены и принимайте жаропонижающие средства.
Видео
https://youtube.com/watch?v=VO_miwuNspI
Внимание!
Информация, представленная в статье, носит ознакомительный характер. Материалы статьи не призывают к самостоятельному лечению. Только квалифицированный врач может поставить диагноз и дать рекомендации по лечению, исходя из индивидуальных особенностей конкретного пациента.
Статья обновлена: 25.07.2019
Частые вопросы
Нужно ли удалять зубы мудрости если они прорезались?
Так нужно ли удалять зубы мудрости? Не обязательно. Если их рост не сопровождается воспалительным процессом и постоянной болью, если восьмерки не подвержены кариесу, можно сохранить их. Удаление зуба мудрости не является оправданным в 100% случаев.
Как понять что прорезываются зубы мудрости?
боль, отдающая в кость челюсти,отек десны,боль при глотании,выраженное поднятие высоты десны,увеличение лимфатических узлов при появлении нижних восьмерок,заложенность носа при появлении верхних восьмерок,повышение температуры,головная боль,Ещё
Как меняется лицо при удалении зубов мудрости?
Удаление зубов мудрости может поменять форму лица. Их наличие или отсутствие никак не влияет на овал лица, поскольку все восьмерки находятся только внутри дуги челюсти.
Сколько по времени удаляют зуб мудрости который не прорезался?
При простом не нужно делать разрез в десне, высверливать кость или накладывать швы. Такая манипуляция длится около 10 минут. Сложное удаление нужно, когда зуб прорезался не до конца, располагается под углом или имеет загнутые большие корни. В таких случаях операция длится около часа.
Полезные советы
СОВЕТ №1
Следите за рекомендациями врача: перед прорезыванием или удалением зубов мудрости обязательно проконсультируйтесь с стоматологом, чтобы получить индивидуальные рекомендации и план действий.
СОВЕТ №2
Соблюдайте правила послеоперационного ухода: после удаления зубов мудрости важно строго следовать рекомендациям врача по уходу за раной, чтобы избежать осложнений и ускорить процесс заживления.